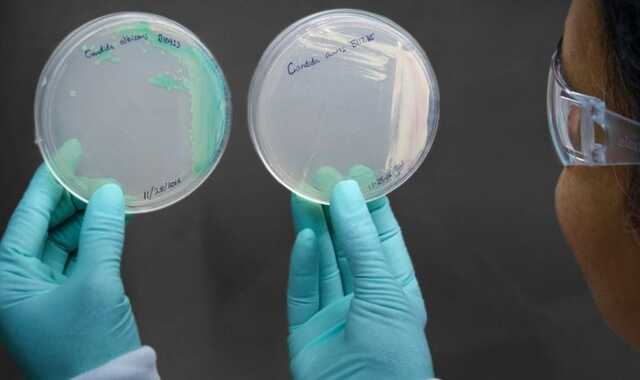
В США зафиксировали вспышку смертельного грибка, который устойчив ко всем препаратам

В США зафиксировали вспышку смертельного грибка, который устойчив ко всем препаратам
В США зафиксировали вспышку смертельного грибка, который устойчив ко всем препаратам
В США, где 27 декабря зарегистрировали более 500 тысяч положительных тестов на коронавирус, впервые зафиксировали вспышку заражения опасным грибком "Candida auris", который является устойчивым ко всем препаратам. Первые три случая произошли в американском штате Орегон.
Об этом сообщает Beckers Hospital Review.
"Candida auris, смертельный, устойчивый к препаратам грибок, обнаруженный у трех пациентов из Сейлема, (штат Орегон), что стало первым случаем инфекции в штате", - говорится в сообщении.
Издание пишет, что 11 декабря в больнице Сейлема был обнаружен первый случай заражения, второй и третий были зафиксированы 23 и 27 декабря.
Candida auris - новый патоген, который вызывает беспокойство, потому что он может вызвать серьезные инфекции, особенно у людей с хроническими заболеваниями, и может быть устойчивым к противогрибковым препаратам.
Сейчас управление здравоохранения США в совместной работе с местными партнерами и CDC расследуют факторы этой вспышки.
Данные органов здравоохранения США указывают на то, что с 2013 года в Штатах было зарегистрировано более 1 150 клинических случаев "Candida auris".
Кроме этого, в 2019 году вспышка этого грибка произошла в больницах Великобритании, где было заражено 200 человек, тогда погибли 8 пациентов.
Теги: пациентыопасностьИнфекцииСША
Коментарі:
comments powered by DisqusЗагрузка...
Наші опитування
Показати результати опитування
Показати всі опитування на сайті
